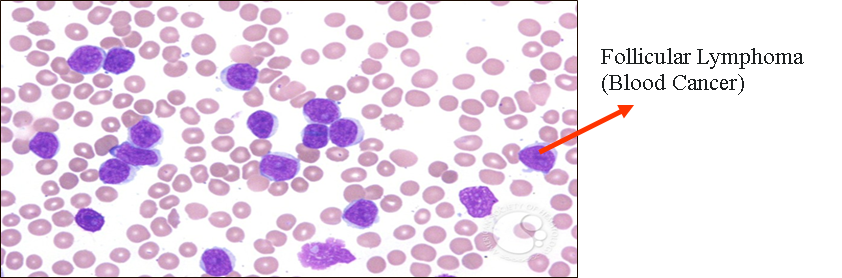
Description of image

Omani Female (name withheld) aged 57 years old was initially diagnosed with stage III follicular lymphoma in 2017. At that time, the patient underwent standard medical procedure following her doctor’s advice. Unfortunately, the disease further transformed into diffused large B cell lymphoma in 2018. Since then, she has started on R-CHOP treatment and 6 cycles of chemotherapy (Benadmustine/ Rituximab). However, the patient experienced various side effects and complications due to the drug administration including abdominal pain, diarrhoea, and diffused painful skin lesions over her lower body.
NK Cell Treatment
Patient underwent a NK cells treatment which consisted of 10 cycles of NK cells over a period of 3 weeks. The patient was cured of advanced stage follicular lymphoma.